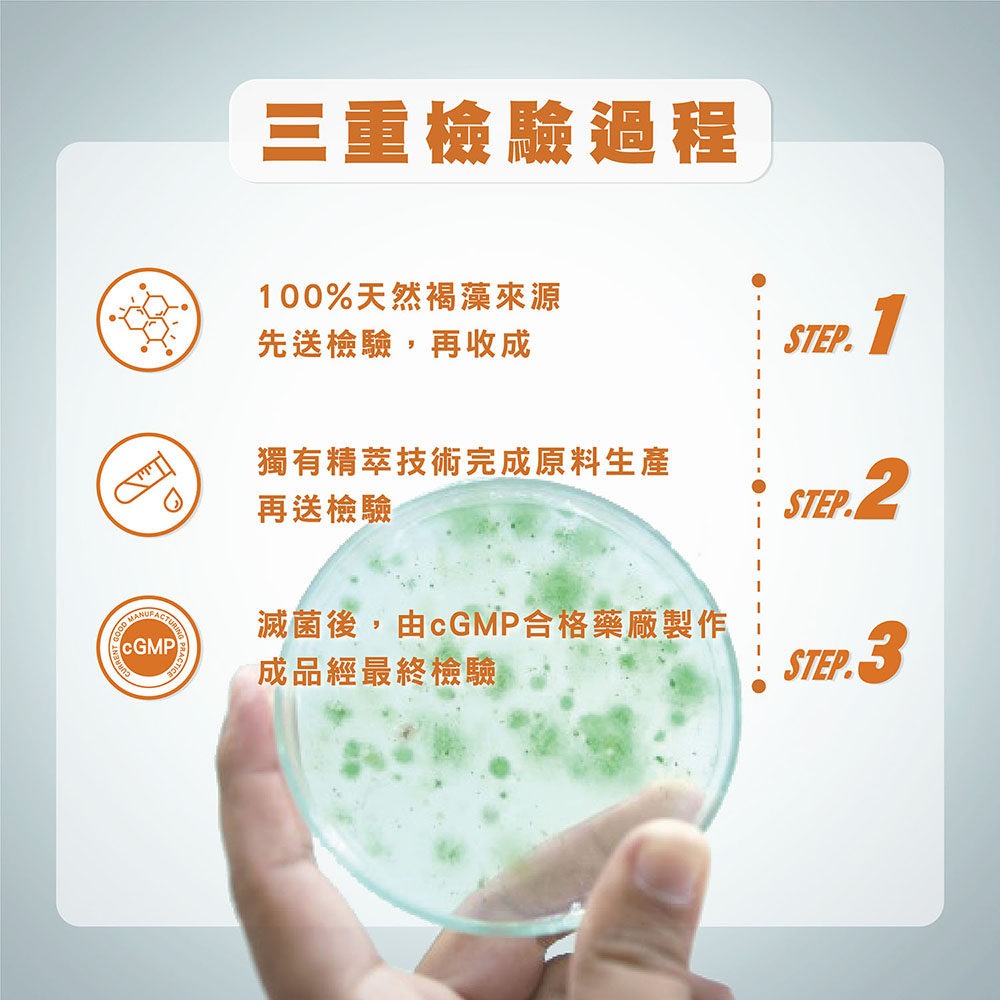
Hi-Q 褐抑定 加強配方 小分子褐藻醣膠 膠囊480顆/盒

【商品名稱:褐抑定小分子褐藻醣膠】
.OliFuco®小分子褐藻醣膠
.僅500道爾頓,吸收率佳
.經人體臨床實驗
.多家教學醫院採用
.專業醫師推薦
※若為短效期(7天內)/生鮮易腐敗食品,不適用七天鑑賞期,除商品瑕疵外,將不提供退換貨服務。
【規格】
品牌:HiQ
規格:625mg±10%x480顆/盒
產地:台灣
成份:如商品外包所示
總效期:2年
包裝方式:外-紙盒;內-PTP鋁箔包裝
包裝內容物:480顆/盒
為禮盒/福袋送禮包裝
【注意事項】
※本商品含有強制性標示過敏原成分,不適合其過敏體質者食用。
※食用方法:建議空腹食用,每日2份共8顆,一次食用,或分次食用均可。若難以吞食,亦可將膠囊中粉末取出,混於食物或流質食物食用。
※保存方式︰請置於乾燥陰涼處,避免陽光直射。【食用前請詳閱包裝上產品說明】